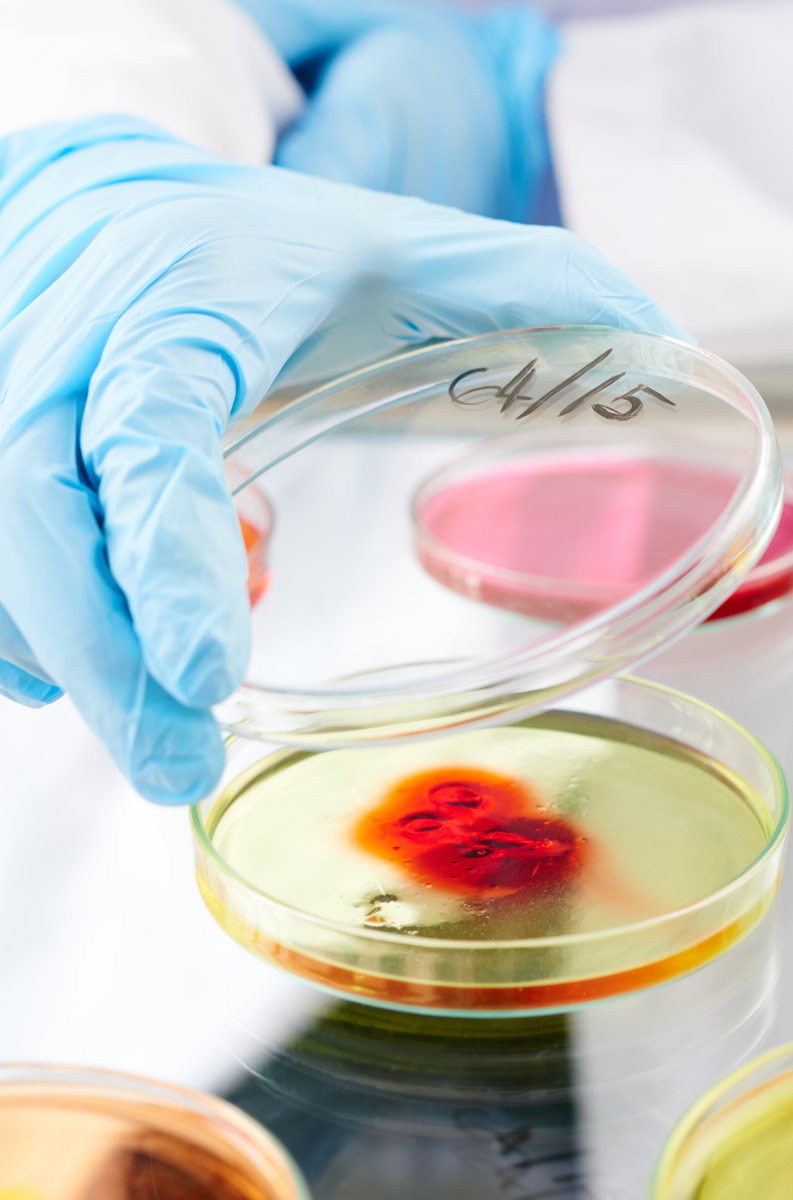
causas-de-las-enfermedades-infecciosas

Infecciosas

¿Qué son las enfermedades Infecciosas ?
Son alteraciones causadas por microorganismos (bacterias, virus, hongos o parásitos) que pueden causar enfermedades.

¿Cuáles son las más frecuentes en las que podemos intervenir?
Infecciones fúngicas: Candidiasis y otros hongos.
Infecciones bacterianas: Yersinia, Borreliosis o Enfermedad de Lyme, Escherichia coli urológico y enteropatógeno, infecciones urinarias recidivantes, diarrea por antibióticos, cistitis, Helicobacter pylori, clamidias, pseudomonas y otras infecciones bacterianas.
Infecciones víricas: hepatitis víricas, herpes, gripe y procesos gripales, prevención de la gripe e infecciones invernales, citomegalovirus, virus respiratorio sincitial, papiloma, mononucleosis infecciosa aguda y crónica, diarrea vírica, COVID19 y otras infecciones víricas.
¿Cuál es la causa?
Los microorganismos ingresan en el cuerpo y causan lesión directa en nuestros tejidos, incluso puede ser a distancia por las toxinas que producen; o bien estimulan una respuesta inmunitaria en nosotros tan intensa que además de intentar destruirlos, se ve afectado el propio tejido donde tiene lugar esa defensa.
¿Cuál es nuestro objetivo?
Dar la información adecuada a la célula para evitar que los microorganismos causantes de enfermedad entren en ella, se multipliquen y la destruyan. Evitar que produzcan toxinas o que se apoderen de la maquinaria celular y la utilicen en su propio beneficio.
¿Cómo podemos ayudar?
Primero debemos realizar un diagnóstico adecuado mediante entrevista, exploración y técnicas diagnósticas de precisión como perfil proteico, tipaje linfocitario, serología y otras.
Cuando tenemos todos los datos, podemos actuar favoreciendo la autorregulación celular con diferentes estrategias: Bioinmunogenética o Bi(G)MED, nutrición y micronutrición; así como otros tratamientos complementarios que el caso concreto requiera.

Particularidades
La Bi(G)Med puede ayudar tanto en infecciones agudas como en crónicas o reactivaciones.
Una infección muy frecuente en enfermedades autoinmunes y cánceres es el virus de Epstein-Barr. Un virus que se encuentra latente en muchos individuos y que, si experimenta una reactivación, entretiene al sistema inmune y no deja que se defienda de otros daños. Su reactivación también puede agotar el sistema inmune produciendo el síndrome de fatiga crónica.
Ahora que estamos en pandemia por el SARS-COV-2, tenemos establecido un protocolo para optimizar nuestra inmunidad, además de dar la información adecuada y precisa a la célula para impedir la entrada del virus a su interior y que no pueda multiplicarse.